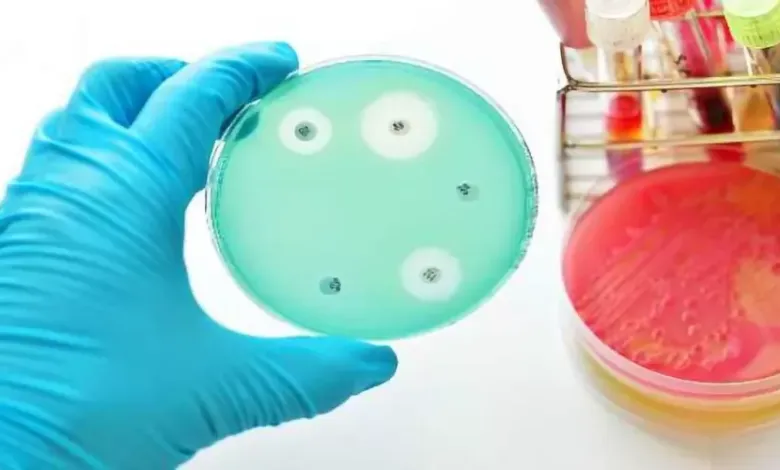

واحد من كل ستة إصابات بكتيرية شائعة حول العالم لم تعد تستجيب للمضادات الحيوية القياسية، وفق بيانات جديدة لمنظمة الصحة العالمية. هذا الرقم المستخلص من مختبرات في أكثر من 100 دولة يظهر كيف تحول مقاومة المضادات الحيوية الإصابات الروتينية إلى أمراض تهدد الحياة.
تشغل منظمة الصحة العالمية نظام GLASS لمراقبة مقاومة المضادات الحيوية واستخدامها عالميًا، حيث يجمع بيانات مختبرية حول المقاومة ويحوّلها إلى تقارير وطنية وعالمية. أظهرت أحدث التقارير أن المقاومة ارتفعت في أكثر من 40% من أزواج الممرض-المضاد الحيوي بين عامي 2018 و2023، ما يؤكد أن مقاومة المضادات الحيوية لم تعد مشكلة مستشفيات نادرة، بل أصبحت سمة شائعة للإصابات التي تُعالج في العيادات حول العالم.
تسجل مناطق جنوب شرق آسيا والشرق الأوسط مقاومة نحو إصابة واحدة من كل ثلاث إصابات للبكتيريا الرئيسية، بينما تسجل بعض مناطق أفريقيا إصابة واحدة من كل خمس إصابات مقاومة، حيث تواجه الخدمات الصحية صعوبة في تشخيص وعلاج الحالات بسرعة. الدول ذات المختبرات الضعيفة والعيادات المزدحمة ونقص الأدوية تشهد مقاومة أكبر وقلة الخيارات عند فشل العلاج الأولي.
واحد من كل ستة إصابات بكتيرية لم تعد تستجيب للأدوية القياسية، حسب منظمة الصحة العالمية
تعتبر البكتيريا سالبة الغرام من أخطر التهديدات، لا سيما الإشريكية القولونية (E. coli) والكليبسيلا الرئوية (K. pneumoniae)، التي تهيمن على الإصابات المقاومة في مجرى الدم وقد تؤدي للإنتان وفشل الأعضاء. تجاوزت مقاومة E. coli أكثر من 40% وK. pneumoniae أكثر من 50% من الإصابات للمضادات الحيوية من الجيل الثالث، وتصل في بعض الدول الأفريقية إلى أكثر من 70%.
تزداد مقاومة المضادات الحيوية “الملاذ الأخير” مثل الكاربينيمات في E. coli وKlebsiella وAcinetobacter وSalmonella، ما يحدّ الخيارات العلاجية للمرضى.
كذلك تفقد أدوية مثل الفلوروكينولونات فعاليتها ضد هذه الممرضات في كثير من المناطق، ما يضطر الأطباء لاستخدام أدوية أقدم وأشد سمية وتتطلب متابعة طويلة بالمستشفى.
يستند نظام GLASS إلى أكثر من 23 مليون إصابة مختبرية مؤكدة من 104 دول، لكنه يعاني نقص الموارد في المختبرات، ما يعني أن الحالات الأكثر خطورة في المجتمعات الفقيرة غالبًا لا تُسجّل. ويُقدّر العدد الفعلي للإصابات المقاومة عالميًا أعلى من التقديرات الحالية، خصوصًا في المناطق ذات الأنظمة الصحية الأضعف.
تشير الدراسات إلى وفاة 1.27 مليون شخص سنويًا مباشرة نتيجة الإصابات المقاومة، و4.95 مليون شخص بشكل مرتبط، ما يجعل مقاومة المضادات الحيوية سبب وفاة أكبر من فيروس HIV أو الملاريا، مع تأثير كبير على الأطفال وكبار السن.
تتوقع التقييمات العالمية ارتفاع الوفيات المباشرة الناتجة عن مقاومة البكتيريا إلى نحو 1.91 مليون وفاة سنويًا بحلول 2050، وأكثر من 8.2 مليون وفاة تشمل حالات تصبح صعبة العلاج. كبار السن سيتحملون معظم الزيادة.
لا تزال نصف دول العالم بلا أنظمة موثوقة لمراقبة مقاومة المضادات الحيوية، ما يدفع الأطباء لوصف مضادات واسعة الطيف بشكل وقائي، مما يزيد المشكلة. وتلعب المختبرات المحلية المحدودة دورًا كبيرًا في زيادة المقاومة وعرقلة العلاج الآمن.
اعتمدت الأمم المتحدة إعلانًا سياسيًا للحد من الوفيات وتحسين الوصول للمضادات الحيوية بحلول 2030، ويشمل تقوية المختبرات، الاستخدام الحكيم للأدوية، ربط الصحة البشرية والحيوانية والبيئية، وزيادة البحث والتطوير في العلاجات الجديدة.
حذر مدير منظمة الصحة العالمية من أن مقاومة المضادات الحيوية تتقدم بسرعة أكبر من الطب الحديث، مما يعرض الأسر عالميًا لمخاطر متزايدة. لمواجهة هذا الخطر، يلزم الالتزام بالنظافة في المستشفيات، برامج التطعيم، مياه صالحة للشرب، وصرف صحي آمن، مع وصف المضادات فقط عند الضرورة واختيار أدوية ضيقة الطيف وإيقاف العلاج عند عدم الحاجة.
المصدر: المستقبل الأخضر